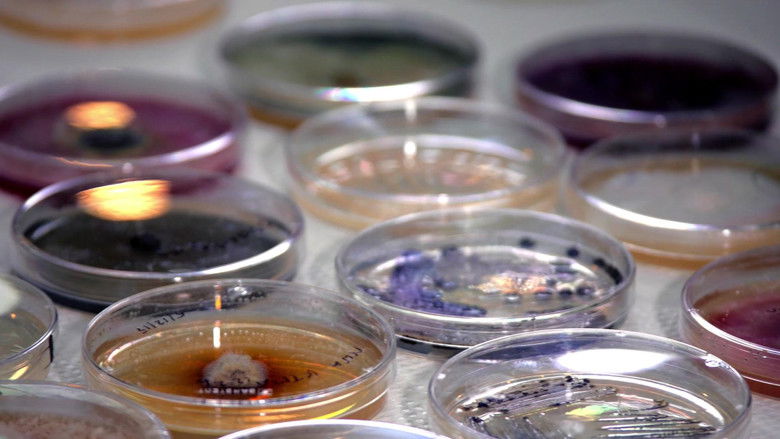
Backdrop

The Kingdom: How Fungi Made Our World is a documentary movie released in 2018. The film has gained attention for its storyline, performances, and production quality. Viewers can explore detailed information including cast, ratings, plot summary, and similar recommendations on CinemaToday.
You find fungi in Antarctica and in nuclear reactors. They live inside your lungs and your skin is covered with them. Fungi are the most under appreciated and unexplained organisms, yet they could cure you from smallpox and turn cardboard boxes into forests. They could even transform Mars into Eden. There are vastly more fungi species than plants and each and every one of them play a crucial role in life’s support systems. Join us on a journey into the mysterious world of Fungi to witness their beauty, unravel their mysteries and discover how this secret kingdom is essential to life on Earth, and may in fact hold the key to our future.
The cast of The Kingdom: How Fungi Made Our World features talented actors who bring the story to life with memorable performances.
8.3/10
12 votes
0
Popularity Score
The Kingdom: How Fungi Made Our World has received positive audience ratings, reflecting its popularity and viewer engagement worldwide.

CinemaToday does not host, upload, or stream any movies or TV shows.
This product uses the TMDB API but is not endorsed or certified by TMDB.